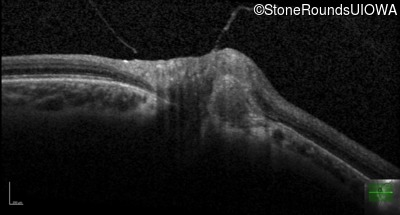
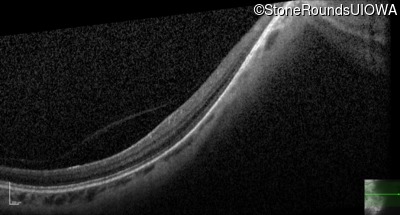
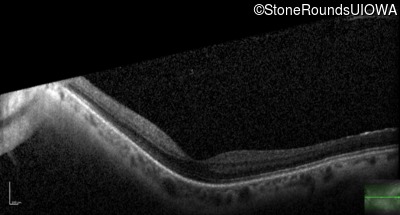
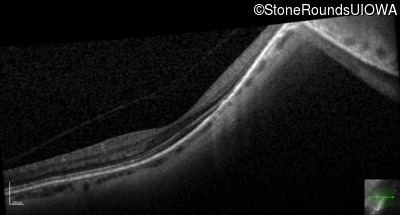
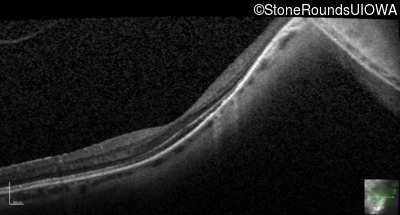
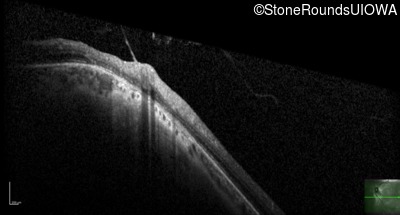
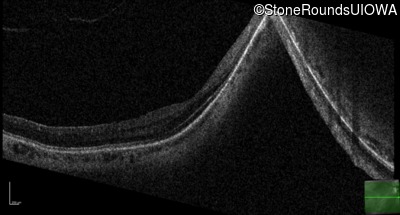

Case
SR598
Student Mode
Stickler Syndrome (IIIE1)
Female
Female
Hidden
SR598
Student Mode
Stickler Syndrome (IIIE1)
Female
Female
History
This 41 year old woman was highly myopic as a child and experienced a rhegmatogenous retinal detachment OS at age 20.
| Refraction OD: | -17.25 +1.00 x 93 |
|---|---|
| Refraction OS: | -18.25 +3.50 x 56 |
Teaching Points
The clinical features favoring the diagnosis of Sticker syndrome in this patient include extensive radial lattice degeneration, a personal and family history of rhegmatogenous retinal detachment, a history of cataract surgery before age 30 (and very high myopia before that), arthritis in her knees and hips and a slightly flattened mid-face.
| Age at visit: 36 years |
| Age at visit: 41 years (Visit 2) |
| Age at visit: 42 years |
| Age at visit: 42 years (Visit 2) |
| Age at visit: 47 years (Visit 2) |
| Age at visit: 48 years |
Diagnosis & molecular findings
| Disease | Gene | Allele 1 variant(s) | Allele 2 variant(s) | Inheritance mode |
|---|---|---|---|---|
| Stickler Syndrome | COL2A1 | Arg785Stop CGA>TGA | AD |